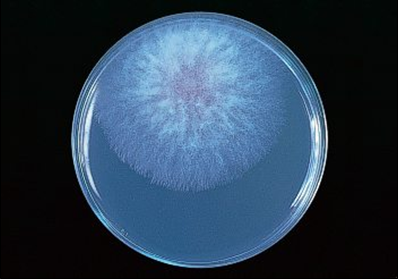
Fusarium graminearum, fitopatógeno, productor de tricotecenos y patógeno oportunista

LISTERIA MICROBLUE AGAR (BASE) Medio modificado para el aislamiento selectivo de las especies de Listeria, y diferencial para L.monocytogenes (ISO 11290-1:1997, ISO 11290-2:2000 MODIFICADAS)
Medio que en su día supuso una revolución ante el Palcam o el Oxford, aunque actualmente es más recomendable el Cromocytogenes por su rapidez.
COMPOSICIÓN
- Peptona de carne 10,0 g
- Extractode carne 1,00 g
- Extracto de levadura 3,00 g
- Almidón de maíz 1,00 g
- Glucosa 0,50 g
- Mannitol 10,0 g
- Cloruro de Litio 15,0 g
- Cloruro Sódico 5,00 g
- Mezcla cromogénica A 0,02 g
- Agar-Agar 12,0 g
(Fórmula por litro)
pH final: 6,8 ± 0,2
En vial aparte 50 ml:
Mezcla cromogénica B 5,00 g
Ceftacidina 20,00 mg
Polimixina B Sulfato 10,00 mg
Acriflavina 20,00 mg
(Fórmula por litro final de medio)
PREPARACIÓN
Fundir en agua hirviendo un frasco con 100 ml de medio. No sobrecalentar: en cuanto esté homogéneamente licuado, transparente, debe retirarse del baño María. Si el medio, violeta, ha virado a verdoso o amarillento durante su almacenamiento o fusión, por acidificación atmosférica, es imprescindible ajustar ahora el pH con NaOH 1 N hasta que el medio esté violeta.
Enfriar a 50°C, hasta que el frasco esté caliente pero sea soportable por la mano, y aún esté líquido. Añadir entonces, a cada frasco de 100 ml de medio base, 2 ml del suplemento estéril MICROBLUE (SMT260), pinchando con jeringa el frasco de 50 ml de suplemento (c.s.p. 25 frascos x 100 ml de MICROBLUE Agar BASE, para elaborar 125-175 placas).
Agitar bien y verter sobre 5-7 placas Petri estériles. Dejar solidificar y una vez frío voltear las placas para que el agua de condensación no barra la superficie del medio. Cerrar con cinta de sellado (Ref. MICROKIT: PARAFIL). Las placas que no se vayan a usar en el día se guardan en nevera (4-15°C) y en total oscuridad hasta su utilización (máximo una semana). Si se desea sembrar en masa, verter 1 ml de muestra cuando se están elaborando las placas.
PARA USO EXCLUSIVO EN LABORATORIO. MANTENGA LOS FRASCOS DE AGAR Y DE SUPLEMENTO A 4-15°C, EN TOTAL OSCURIDAD. PRESENTACIÓN: MEDIO SÓLIDO PREPARADO EN FRASCO ESTÉRIL 100 ml, CÓDIGO RPL073. SUPLEMENTO LÍQUIDO PREPARADO EN FRASCO ESTÉRIL 50 ml, CÓDIGO SMT260
CONTROL DE CALIDAD DEL MEDIO
Realizado en nuestro laboratorio; es prudente repetirlo en su laboratorio siempre que varíen las condiciones (más de 3 meses sin usar, tras desinfectar el laboratorio, tras conservar a alta Tª por fallos de refrigeración, cuando adquiere aspectos extraños aunque no haya llegado la fecha de caducidad teórica de su etiqueta…)
DESHIDRATADO: No existe. PREPARADO: Agar base violeta, homogéneo, traslúcido. Suplemento amarillo, translúcido, puede contener precipitados por su elevada concentración, que se disuelven tras agitar y añadir al medio base.
CONTROL DE CRECIMIENTO (48 h a 37°C aproximadamente):
- Listeria monocytogenes MKTN 7644, correcto, colonias color amarillo limón o crema en 24 horas, con halo amarillo a las 48h. Con respecto a PCA estandarizado*, recuento 97-103%, pero de forma selectiva.
- Listeria innocua MKTN 12210, correcto, colonias color amarillo limón o crema con halo amarillo en 24 horas. Con respecto a PCA estandarizado*, recuento 103%, pero de forma selectiva.
- Listeria ivanovii MKTA 19119, Listeria grayi MKTA 19120, Listeria seeligeri ATCC MKTA y
- Listeria welshimeri MKTA 35897, correcto, colonias blancas, amarillas, naranjas o violáceas, pero sin halo amarillo en 48 horas. Con respecto a PCA estandarizado*, recuento 92% (L.ivanovii), 87% (L.grayi) y 83% (L.welshimeri), pero de forma selectiva.
- Staphylococcus aureus MKTA 25923, parcialmente inhibido, colonias tardías (48 horas) blanquecinas o amarillas con medio amarillo. Con respecto a PCA estandarizado*, recuento 39%.
- Enterococcus faecalis MKTA 29212, parcialmente inhibido, colonias tardías (48 horas) blanquecinas. Con respecto a PCA estandarizado*, recuento 22%.
- Pseudomonas aeruginosa MKTA 10145, inhibido
- Proteus vulgaris MKTA 13315, parcialmente inhibido, colonias tardías amarillas, medio amarillo. Con respecto a PCA estandarizado*, recuento 21%.
- Bacillus cereus MKTA 10876, colonias céreas, blanquecinas. Con respecto a PCA estandarizado*, recuento 78%.
* El que cumple con recuperación superior al 92-125% con respecto a cepas cuantitativas trazables a la cepa tipo. Incertidumbres detectadas entre todos los lotes a lo largo de un año (la mayoría de la incertidumbre se debe a la cepa y a la proporción de cepas acompañantes inoculadas, no al medio).
MODO DE EMPLEO E INTERPRETACIÓN DE RESULTADOS
Para aislamiento, sembrar el caldo de enriquecimiento en superficie, por agotamiento. Para recuento, sembrar 0,1 ml del caldo por extensión, con asa de Digralsky (VRR154, VCL155) o bien 1 ml en masa cuando se están elaborando las placas. Incubar 24-48 horas a 35-37°C aproximadamente. Medio altamente selectivo para el género Listeria, y diferencial para L.monocytogenes: sólo L.monocytogenes crece con colonias amarillo-anaranjadas (desde caldo LEB, crema desde Fraser), con halo amarillo en el medio en 48h. Alguna cepa de L.innocua y de L.welshimeri podría crecer con colonias amarillas (desde caldo LEB, crema desde Fraser), en el primer caso con halo amarillo en 24 h y en el segundo sin halo; para descartarlas y confirmar Listeria monocytogenes, añadir sobre la colonia presuntiva un disco de Aminoacyl--naftilamida (M-IDENT®-DISCOS L.monocytogenes KIN023). Incubar 2 horas a 35-37°C aproximadamente.
Añadir 2 gotas de solución de p-dimetilaminobenzaldehido (gotero del kit KIN023). Si se desarrolla inmediatamente en el disco un suave color asalmonado, o no se desarrolla ningún color, se confirma la colonia como perteneciente a la especie Listeria monocytogenes. El resto de especies de Listeria generan un viraje del disco a amarillo. Un estudio interno del medio MICROBLUE con 40 cepas indica que la selectividad es del 97,5 % para el género Listeria y el carácter diferencial resultante fue: colonias amarillo-anaranjadas en 24 h, con halo amarillo en 48 h, y sin viraje a amarillo de los discos, en el 100% de las cepas de L.monocytogenes y en el 0% en cepas de Listeria sp. non monocytogenes.
El usuario final es el único responsable de eliminar los microorganismos de acuerdo con
la legislación medioambiental vigente. Autoclavar o inundar en lejía antes de desechar a la basura.
Si desea más información sobre nuestros LISTERIA MICROBLUE AGAR (BASE) , rellene nuestro formulario de contacto http://www.medioscultivo.com/contacto . O si lo prefiere póngase en contacto con nosotros a través de nuestro correo electrónico microkit@microkit.es o por teléfono en el nº 91-897 46 16
http://LISTERIA-CROMOCYTOGENES-OTTAVIANI-AGOSTI-AGAR.pdf
https://www.microkit.es/monograficos/3-Listeria-monocytogenes-monograf–a.pdf